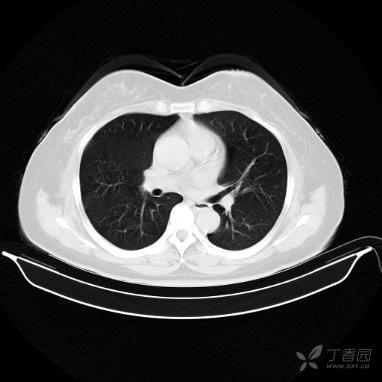
右肺上叶改变?

右肺上叶图片

结合肺段模式心室层面(见图),选出右肺上叶的组成
图片尺寸348x256
右肺上叶这个条索样是什么?
图片尺寸1920x1080
右肺上叶改变?
图片尺寸382x382
【讨论】右肺上叶结节78756
图片尺寸512x512
这是在弋矶山拍的ct,图2,3,4都是在右肺上叶,所以手术切 - 抖音
图片尺寸800x559
请教右肺上叶是什么?
图片尺寸780x1040
经支气管镜下治疗拒绝手术的早期肺癌患者一例
图片尺寸512x512
与肺对话身体是某个课题的完结篇
图片尺寸1080x845
肺部结节_肺部结节就诊指导 - 好大夫在线
图片尺寸718x719
高树庚教授认为,解剖性部分肺叶切除术的优势明显,避免了小结节定位的
图片尺寸335x462
右上肺该考虑什么
图片尺寸2736x3648
求助万能的丁香园友,我妈妈胸部ct发现右肺上叶尖段小结节,先谢谢大家
图片尺寸960x1280
问诊分析:这样的右上肺实性结节像不像恶性? - 好大夫在线
图片尺寸941x849
王留锁,男,55岁,间断咳嗽咳痰5年,右肺上叶团块及条片
图片尺寸3024x4032
ct医师大型医用设备上岗证呼吸循环系统章节练习20160321
图片尺寸448x621
求助万能的丁香园友,我妈妈胸部ct发现右肺上叶尖段小结节,先谢谢大家
图片尺寸960x1280
发现肺结节如何判断结节的位置和良恶性精辟解析来了
图片尺寸1051x616
胸膜与肺的结构示意图
图片尺寸414x276
如此详细的肺部影像解剖有点儿酷
图片尺寸624x624
男46,体检发现右肺上叶占位,有结果
图片尺寸4064x3048